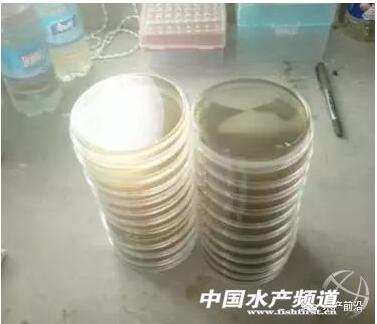

5亩地年赚百万,看科技与养虾如何碰撞出火花
在中国的养虾界,年轻的脸孔越来越多
新农人是指具有科学文化素质、掌握现代农业生产技能、具备一定经营管理能力,以农业生产、经营或服务作为主要职业,以农业收入作为主要生活来源,居住在农村或城市的农业从业人员。
10月28日是一个晴好的日子,屋外略显寒冷,但位于山东省威海乳山口镇蜊子嘴村的养虾大棚却异常热闹,李涛的屋子里又迎来两位登门拜访的村民。由于养虾技术好、理念科学、待人友善,尽管才第一年养虾,怀抱优异的成绩单已经使李涛成为当地的养虾新星,老乡们也惊讶养虾原来还可以这样“玩”,所以时不时前来取经,接待客人已经成为李涛生活中的一部分。
坐在面前的李涛,89年生,面容白皙清秀,笑起来如冬日阳光般温暖。本科时在青岛科技大学修读化学专业的李涛,毕业后跨专业考上中国海洋大学研究生,研究生物饵料方向。这仅仅是一个开始,为了蠢蠢欲动的梦想,研究生毕业一年后,他选择了一条充满风险与挑战的道路——养虾,现在已然是一个地地道道养虾创业的“新农人”,而他交出的成绩单也颇为惊艳:早造虾盈利55万,困难重重的中造虾更上一层楼,盈利61万。
同样选择水产,却不再被传统观念束缚;同样面朝大海汗流浃背,内心却春暖花开;同样是养虾,得益于高科学文化素养,不再像传统的虾农迷失在混乱无章的行业大潮中,李涛正在用新理念、新技术,讲诉着他和大海的故事,也演绎着新一代水产养殖业的希望。
话题是从虾开始的,关于养虾,李涛总有一些说不完的话,我们试着在谈话中走进李涛的养虾世界。
“你是从什么时候开始接触养虾的?” “2011年,我跨专业考上中国海洋大学研究生,就读于水产学院马甡教授甲壳动物增养殖实验室,主攻生物饵料及营养免疫方向。我一直非常感激我的导师,在研究生求学期间,从科研到为人处世,马老师教给了我太多东西,虽然已经毕业两年多了,但我还是会定期的回到实验室,跟马老师请教生产中碰到的一些疑难杂症,继续接受老师的教诲。我现在也和实验室有一些合作,除了为实验室提供研究所用对虾苗种外,也正尝试共同开展一些养殖技术方面的探索实验,助力产学研的有机结合和转化。
研究生第二年就到胶州一个工厂化养殖场做课题,这一待就是两年,2014年毕业后,乳山当地一个养殖场缺技术员,我就过去了。其实上学那会儿就有考虑过要走养虾这条路,想在技术这一块深挖一下,学以致用嘛。”
“养虾风险那么高,而且和你研究生的身份有点出入,为什么还义无反顾出来创业?” “我觉得水产是一个可以安身立命的行当,而且水产业的空间还是比较大的,是一个朝阳产业,仍有很多东西值得我们去摸索。”
“中国海洋大学的研究生我考了两年才考上,对水产也可以说是发自内心的喜欢。特别是有些技术在我研究生期间摸索后已经比较成熟,心里也有些想法,因此在养殖场待了一年后,觉得如果有条件还是要尝试一下,所以15年底我就开始自己建棚养虾了。创业的过程却非常艰辛,从精神压力到资金压力,折磨的人身心俱疲,有时甚至想要放弃,但是,转念一想,不经历风雨,怎能见彩虹,咬着牙,弓着腰,一步步完成了养殖场的规划、基建、调试、投产,非常感谢那些在我最困难的时候帮助过我的人,也想对我的妻子说声谢谢:是你的无怨无悔,默默支持,让我不断前行。也祝愿那些走在创业路上的同道中人:加油,不要轻言放弃!”
“另外就是性格使然,我的性格偏内向,不喜欢受约束,也不喜欢在外面跑,比较喜欢静静地做些事情。再往上推,大概就是我的水产情结,小时候依水而居,抓鱼捕虾没少和水产打交道,童年的爱好和经历对我的择业影响非常大。”
“你是经过专业的科学素养训练的,和老百姓的养殖思维方式是否不一样呢?” “是的,你也可以看到,从整个养殖周期的安排、养殖理念、基础设施都不一样,与传统的养殖模式还是有很大出入的。毕竟我是学这个的,有一定的专业基础,沉浸在这个行当也好几年了,对它的风险以及薄弱环节多多少少都有了解,不会像外行那样刚进来两眼一抹黑。”
茶壶咕咕响着,蒸汽腾腾,屋内一片安静详和,面前年轻的小伙子腼腆的笑着。
“介绍一下你整个养殖理念吧?” “最重要的还是要以科学的理念来从事水产养殖,毕竟养虾属于高危行业,如果盲目操作的话风险肯定很高。”
“例如检测这一块,我们有一套相对完善的检测设备,包括水质化验,总菌检测,我们都会定期去做。还有就是养殖理念,现在的老百姓比较盲目,包括用药、用料、选苗,跟风现象比较严重,不能甄别东西的好坏真伪,而我们有专业基础,看问题会比较深刻一些,不会被表面的东西所蒙蔽。”
“比如用菌,我都会先做镜检,评估活菌的数量及活力,再决定这个产品是否能用。一些厂家也会发样品过来让我们做实验,前段时间一个厂家的产品出了点问题,我们现在也在和厂家积极沟通,最终的目的就是希望他们能研发出一些能切实帮助到老百姓的产品,而不是一些假大空的东西。我们也会为老百姓提供服务,有新成果也会拿出来和大家分享。”
“你这个实验室也算是周边的一个检测机构了,老百姓肯定能从中受益不浅,室验室是公益性的吗?” “是的,是公益性的。因为大家都比较熟,有什么问题拿出来大家可以互相探讨学习,有些问题一交流思维就开阔了,闭门造车肯定是不行的。”
“建实验室应该花了不少钱吧?” “实验室的成本并不高,我这个实验成本1.5万左右,有条件的养殖场都可以做到,养殖户经过简单的培训也比较容易掌握。”
“你养虾一年了,觉得最难最难的环节是什么?” “我觉得还是养殖户的思路不清晰,如果思路明确的话有很多问题都能迎刃而解。养殖户没有主见,没有独立思考的能力,老变来变去跟风老肓从,这是养殖业现存的最大问题。这是意识层面的,如果从技术层面上讲,最难的就是水质调控这一块。”
“能介绍一下你调控水质的方法或思路吗?” “我也一直在摸索改进,通过收集菌相、藻相、水体理化指标等一系列数据,探索一套行之有效的调水方法。总的来说,我们侧重于使用益生菌调控水质,全程基本不使用化学类消毒剂,从布苗后就开始着力培养水体的硝化转化系统,配合养殖系统的高效集排污手段,再结合定期的活化补菌和添加适宜适量碳源,通过调节水体微生态体系,尝试探索一种“微絮团养殖模式”,从根本上解决养殖后期的氨氮、亚硝酸盐等理化超标的痼疾。”
“所谓的“微絮团养殖模式”,有别于传统“生物絮团养殖模式”的“零交换”操作,借助于系统的高效集排污,通过高频高效低量的排水操作,移除系统内的大部分有机废物,缓解系统负荷,再借助于有益菌的补充和碳氮比的调控,配合适量的新水注入,维持养殖系统菌相藻相的动态平衡。我个人认为,“微絮团模式”在碳源用量方面要远远低于“生物絮团模式”,而且系统的稳定性更高,操控风险和难度大大降低,更便于养殖户掌握运用,但是针对不同养殖周期的一些操作细节还有待进一步的探索,比如碳源的添加量及补充频率等。另外还定期对水体的弧菌、总菌进行检测,为选择菌种和添加碳源提供数据支撑。”
“多久做一次弧菌检测?” “一般5天做一次,如果出现问题,我们会做综合检测,平时也会做一些不定期的抽检,多种手段结合。”
“如果发现弧菌超标了怎么处理?” “我一般使用益生菌配合生物杀菌剂(蛭弧菌)进行控制。但是益生菌处理起来会有一个周期,如果问题比较严重的话,我会使用较为温和的消毒剂,比如碘制剂进行处理。也会通过换水处理,但我们整体的交换量并不高,到后期每天的交换量也只有15%左右,还是比较节能的,没有其它地区那种大排大灌的情况。”
茶过三巡,早晨的冷雾渐渐退去,屋外的空气开始暖和起来,前来拜访的两位老乡意犹未尽。
“现在种苗行业混乱,你对挑选虾苗有什么看法?” “虾苗市场鱼龙混杂,我建议养殖户选苗一定要选大厂家、大品牌的虾苗。我自己去选苗也会带上检测盒、弧菌板,对虾苗和水体进行检测,包括白斑、桃拉病毒我们也会做检测。”
“最近养殖户普遍遭遇对虾养不大的困境,多半也与所选种苗携带肠孢虫有关系,一定要引起大家的重视。青岛黄海水产研究所已经研发推广一系列现场快速高灵敏检测试剂盒,比如WSSV、TSV、EHP、IHHNV等都可以迅速检测,建议大家可以尝试一下。另外,值得一提的是,从在养殖场做课题,到做技术员,再到自己建棚养虾,我所经历的养殖周期也有10造,其中6造是使用海壹种苗,而且6造均告成功,个人认为海壹种苗是比较稳健的,而且,我也去海壹林梧、昌洒等良种场实地考察过,对其所贯彻的生产理念和苗种检测标准也非常认同,一点个人经验,拿出来跟大家分享一下,因为我切身的知道选择一份好的种苗对整个养殖环节是多么的重要。万事开头难,开始就错了,以后的任何付出都是在改错。”
“对饲料有什么要求吗?” “我建议养殖户选料不要肓目追求价格,购买一些便宜的饲料,还是要看性价比。也不要盲目追求高蛋白料、高价料,特别是现在市面上很多功能性饲料,很多产品的宣传点都是噱头,感觉雷声大雨点小,不能解决实质上的问题。”
“像工厂化养殖模式,我不建议使用高蛋白的饲料,使用42个蛋白就足够了。工厂化养殖属于高密度,水体的负担本来就大,如果蛋白太高,会造成水体碳氮比偏低,从而影响微生物的繁殖。碳氮比一般在20:1时有利于微生物的繁殖,而使用43个蛋白的料,碳氮比一般只有8-10左右,已经非常低了,要补充大量的碳源才能解决这个问题,而且残留的蛋白质也会增加塘底的负担,从而增加养殖的风险。”
“尤其是冬造虾,我建议不能为了追求生长速度而使用高蛋白饲料,尽管可能短期内的生长速度快了,但水体的负担大,可能会造成最终养殖结果的失败。”
“有一个方法我想推荐给大家,生物饵料比如冰冻大卤虫,在工厂化养殖的应用将会是一个趋势,但需要注意生物安全性的问题。建议选用大厂家的天然卤虫,而不是人工用鸡粪等培养的,这些产品的质量非常令人担忧。另外,我们采购的冰冻卤虫都是经过检测合格的,而且入库之前还会再作检测,尽量保证产品的安全性。”
“我的投喂理念也不一样,大部分养殖户使用卤虫是为了促进生长,当主食用的,因此他们的投喂量会偏高一些,而我们使用大卤虫是为了为了提高对虾的免疫力,当零食用的。使用量会少一些。”
“今后还会在哪些方面改进?” “我感觉学习养虾是永无止境的,今年我养了三造虾,每一造都会发现新的问题,并做出一些新的改进,一直都成长进步。我一直想研究出一套复制性强的技术体系,特别是现在很多养殖户失败的原因就出在工程设施上,希望通工程设施的创新,比如在集排污的手段、集排污的动力、提高增氧效率的方法上做一些改进,以提高养殖的成功率。”
茶过五味,离开李涛的养殖基地时已晴空朗朗,我看到李涛鞋子上沾有泥土,猛然被一句歌词击中脑袋:捡起被时间碾碎的勇气,让双脚沾满清香的泥。
笔者手记 “新农人”是近几年兴起的一个代名词,在这个群体中,不乏海归、城市青年、返乡高学历人士、成功商人等人士,笔者在各地的走访中也发现,越来越多的高素质年轻人开始进入水产养殖业,无论你是否愿意接受,现状就是大浪淘沙,新人换旧人。水产养殖业比想象中更为复杂,但其转型之路已初现端倪,各种高科技含量的技术、设备、理念、养殖模式正在改写着中国水产养殖业的历史,而这首要的推动力量就是人才。
可以预见的未来是,由于这群年轻人加入新鲜的血液,水产养殖的价值会逐渐被发现和重视,并且重新定义。
未来也已经很清晰明,做水产不再是一种被动选择的身份,不再像大学调配专业只能无奈接受,水产养殖业将会是一种新型的职业选择,甚至是一个体面的、令人羡慕的职业。虽然路途艰辛,充满挑战,但是“新农人”的生命力也远远超出大家的想象,正是他们的理想和坚守,终有一天,我们的水产业、我们的“新农人”一定会“面朝大海,春暖花开”。
附:李涛养殖过程中所使用的设备以及弧菌培养基的简易制作方法(一起来感受科技的力量)
李涛演示了快速倒平板的方法,方便养殖场现场倒置平板。自制平板单个基础成本约1元,市售成品板在5-10元不等,因此,自制平板简单易操作且物美价廉。(建议现倒现用,自制平板不要长时间储存,防止感染杂菌)。
第一步:秤取培养基11.25克,置于不锈钢小盆中。
第二步:量取125毫升纯净水,不要使用自来水,防止有余氯影响。
第三步:加水入到培养基中,使用电磁炉加热,文火加热5分钟左右即可,文火加热时不需要搅拌。注意不要使用大火快火,防止暴沸及粘底。
第四步:冷却降温至55摄氏度,以手持时不烫手为准。
第五步:倒制平板,每个培养皿倾倒10毫升左右培养基,从培养皿倾倒,然后向另一侧倾斜,使培养基均匀分布在培养皿表面,11.3克可以倒制12个平板。
第六步:静置冷却30分钟左右(视外界气温,气温低时冷却时间短),当培养基完全凝固时,盖上上盖,倒置于低温处保存,有条件的话置于冰箱保鲜柜储存,冬季置于户外即可。
上一篇: 2016中国(舟山)海洋生物蛋白新技术与应用发展论坛开幕
下一篇: 海南首笔罗非鱼养殖收入保险落地